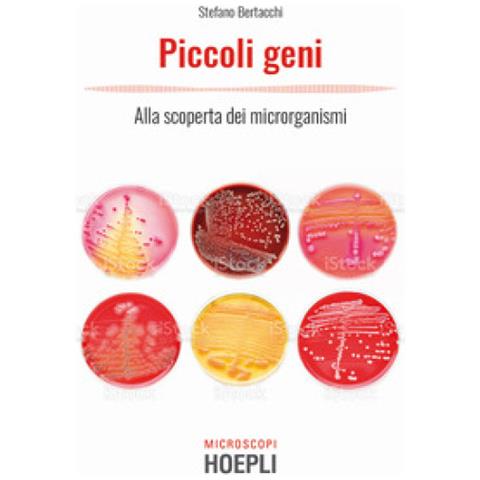
Stefano Bertacchi - Piccoli Geni. Alla Scoperta Dei Microrganismi - Foto 1

HOEPLI Stefano Bertacchi - Piccoli Geni. Alla Scoperta Dei Microrganismi
Pochi pezzi - Fino ad esaurimento scorte
Pochi pezzi - Fino ad esaurimento scorte
€ 14,99
AGGIUNGI AL CARRELLO
Venduto e spedito da ePRICE

Altri 2 venditori a partire da € 37,99
- Informazioni legali
- Ne hai uno da vendere?
- 9788820399962
- 211897652
Sicurezza per i prodotti destinati ai consumatori
Immagini sulla sicurezza
Produttore
Responsabile all'interno dell'UE
Descrizione
Un fantastico viaggio nel microcosmo, in cui le cellule sono capaci di farsi la guerra, ma allo stesso tempo di collaborare anche con esseri viventi ben più grandi, come l'uomo. Dal fondo dell'oceano all'interno della bocca, tanti sono i luoghi abita...
Scopri di piùCaratteristiche e scheda tecnica
Caratteristiche principali
- AutoreStefano Bertacchi
- Anno pubblicazione2021
- Pagine150
- EAN9788820399962
2026-04-28T14:28:32.000Z | 8ca3c59